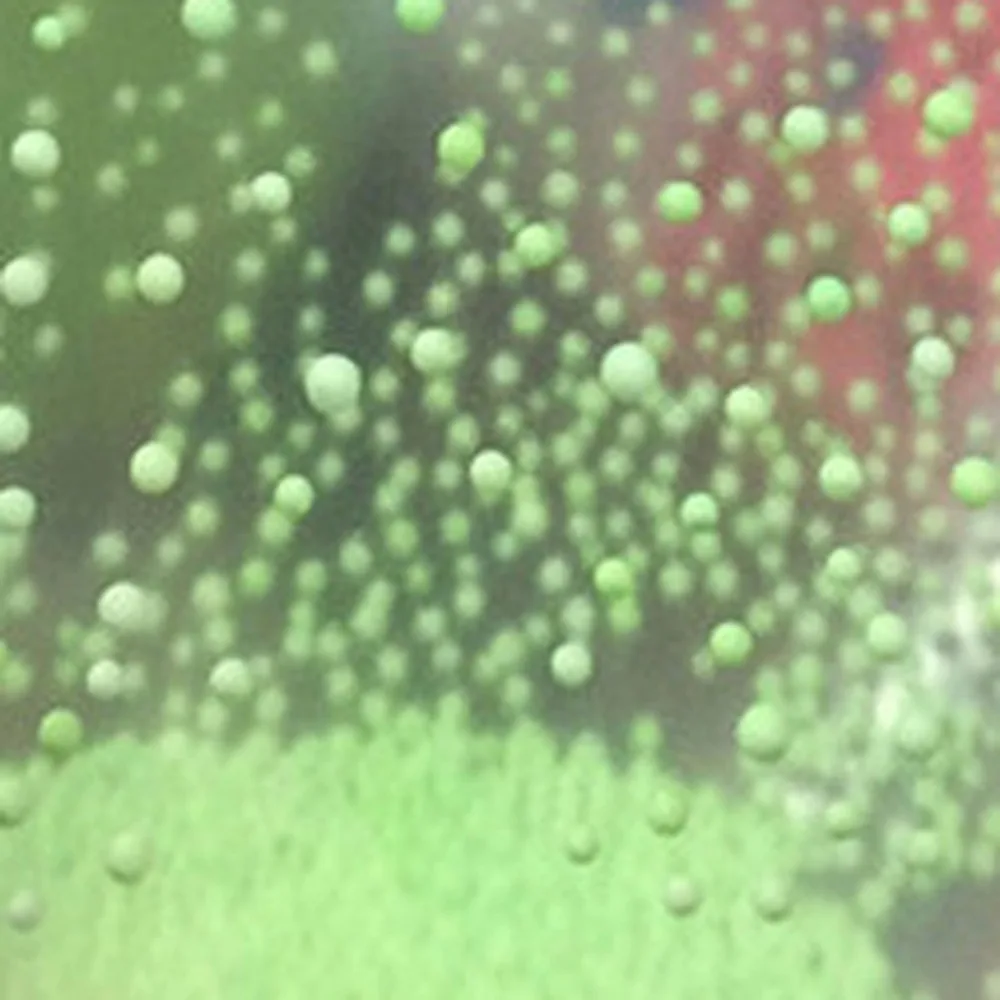
Креативный волшебный шар-игрушка | Дом и сад

Новое поступление
Магазина Legends Pets House Store работает с 09.07.2018. его рейтинг составлет 77.8 баллов из 100. В избранное добавили 1059 покупателя. Средний рейтинг торваров продавца 4.2 в продаже представленно 1045 наименований товаров, успешно доставлено 10208 заказов. 2104 покупателей оставили отзывы о продавце.
Характеристики
*Текущая стоимость уже могла изменится. Что бы узнать актуальную цену и проверить наличие товара, нажмите "Добавить в корзину"
| Месяц | Минимальная цена | Макс. стоимость | Цена |
|---|---|---|---|
| Mar-21-2026 | 0.20 руб. | 0.37 руб. | 0 руб. |
| Feb-21-2026 | 0.80 руб. | 0.82 руб. | 0 руб. |
| Jan-21-2026 | 0.7 руб. | 0.45 руб. | 0 руб. |
| Dec-21-2025 | 0.16 руб. | 0.31 руб. | 0 руб. |
| Nov-21-2025 | 0.56 руб. | 0.2 руб. | 0 руб. |
| Oct-21-2025 | 0.87 руб. | 0.21 руб. | 0 руб. |
| Sep-21-2025 | 0.7 руб. | 0.98 руб. | 0 руб. |
| Aug-21-2025 | 0.92 руб. | 0.85 руб. | 0 руб. |
| Jul-21-2025 | 0.99 руб. | 0.70 руб. | 0 руб. |
Описание товара

Смотрите так же другие товары: